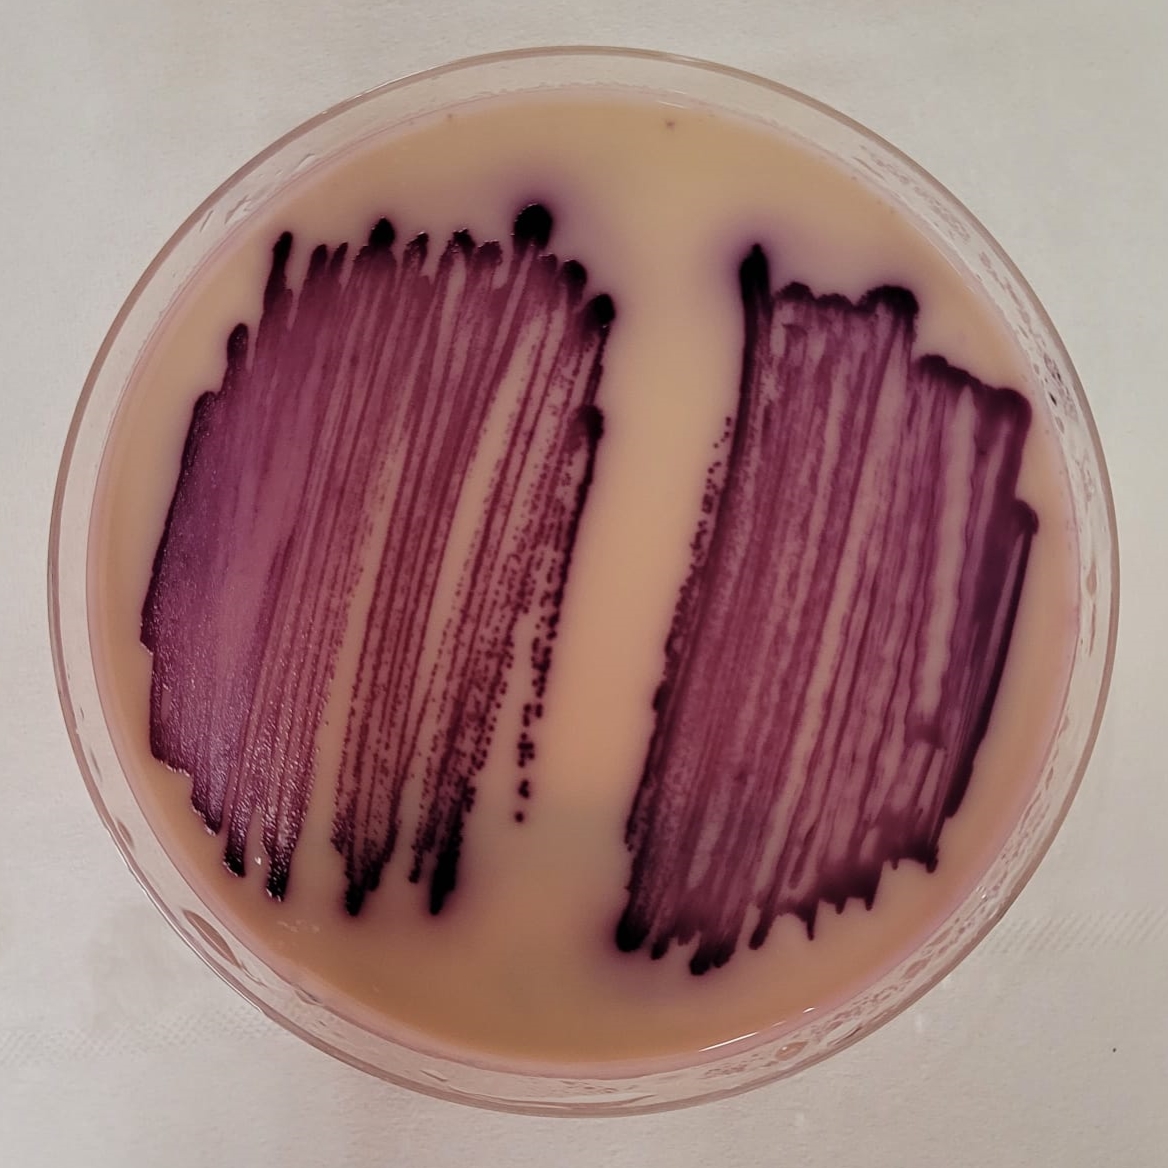
🦠The Art of Bacteria🦠

💎only at 
<a href="/cryptocomnft/">Crypto.com NFT</a>

collection link👉crypto.com/nft/collection…

💎All pictures are original and made by me in the Lab

#NFTGiveaway #NFT #NFTdrop #NFTshill #NFTs #BTC #art #nftart #NFTartist #ETH #CRO #NFTCommunity #NFTGiveaways #cryptocurrency
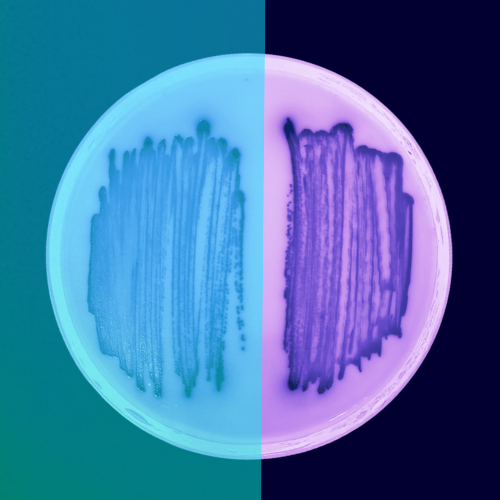
Check out Salmonella's Perspective by Arda NFT at Crypto.com NFT! 

crypto.com/nft/collection… via 
<a href="/cryptocom/">Crypto.com</a>

#NFTGiveaway #NFTCollection  #NFT #NFTdrop #NFTshill #NFTs #BTC #art #nftart #NFTartist #ETH #CRO #NFTCommunity #NFTGiveaways #cryptocurrency

Saija
@saijacronos
NFT artist 🎨
only at 👉 @cryptocomnft 🦁
#FFTB #CRO
ID: 1449881104597626883
https://crypto.com/nft/profile/saija?tab=created 17-10-2021 23:36:09
39 Tweet
56 Takipçi
50 Takip Edilen

💎The Forms💎 🔸Form #15 👉only at Crypto.com NFT 👉crypto.com/nft/collection… #NFTGiveaway #NFT #NFTdrop #NFTshill #NFTs #BTC #art #nftart #NFTartist #ETH #CRO #NFTCommunity #NFTGiveaways #cryptocurrency #cryptoart

🦠The Art of Bacteria🦠 💎only at Crypto.com NFT collection link👉crypto.com/nft/collection… 💎All pictures are original and made by me in the Lab #NFTGiveaway #NFT #NFTdrop #NFTshill #NFTs #BTC #art #nftart #NFTartist #ETH #CRO #NFTCommunity #NFTGiveaways #cryptocurrency

💎CRYPTO T-REXES: ERROR 404 🦖 💎live now only at Crypto.com NFT 💎only official link👉crypto.com/nft/collection… #NFTGiveaway #NFT #NFTdrop #NFTshill #NFTs #BTC #art #nftart #NFTartist #ETH #CRO #NFTCommunity #NFTGiveaways #cryptocurrency #cryptoart


💎The Ghost🙌 collection link 👉crypto.com/nft/collection… 🔷only at Crypto.com NFT #NFTGiveaway #NFT #NFTdrop #NFTshill #NFTs #BTC #art #nftart #NFTartist #ETH #CRO #NFTCommunity #NFTGiveaways #cryptocurrency #cryptoart


💎In Your Head🙌 collection link 👉crypto.com/nft/collection… 🔷only at Crypto.com NFT #NFTGiveaway #NFT #NFTdrop #NFTshill #NFTs #BTC #art #nftart #NFTartist #ETH #CRO #NFTCommunity #NFTGiveaways #cryptocurrency #cryptoart

💎Regrets🙌 collection link 👉crypto.com/nft/collection… 🔷only at Crypto.com NFT #NFTGiveaway #NFT #NFTdrop #NFTshill #NFTs #BTC #art #nftart #NFTartist #ETH #CRO #NFTCommunity #NFTGiveaways #cryptocurrency #cryptoart


💎The Colors of Madness🙌 collection link 👉crypto.com/nft/collection… 🔷only at Crypto.com NFT #NFTGiveaway #NFT #NFTdrop #NFTshill #NFTs #BTC #art #nftart #NFTartist #ETH #CRO #NFTCommunity #NFTGiveaways #cryptocurrency #cryptoart


💎The Galaxy🙌 collection link 👉crypto.com/nft/collection… 🔷only at Crypto.com NFT #NFTGiveaway #NFT #NFTdrop #NFTshill #NFTs #BTC #art #nftart #NFTartist #ETH #CRO #NFTCommunity #NFTGiveaways #cryptocurrency #cryptoart


🦠The Art of Bacteria🦠 💎only at Crypto.com NFT collection link👉crypto.com/nft/collection… 💎All pictures are original and made by me in the Lab #NFTGiveaway #NFT #NFTdrop #NFTshill #NFTs #BTC #art #nftart #NFTartist #ETH #CRO #NFTCommunity #NFTGiveaways #cryptocurrency

so much LOVE 💙 #NFTGiveaway #NFTCollection #NFT #NFTdrop #NFTshill #NFTs #BTC #art #nftart #NFTartist #ETH #CRO #NFTCommunity #NFTGiveaways #cryptocurrency crypto.com/nft/collection… via Crypto.com

Check out Salmonella's Perspective by Arda NFT at Crypto.com NFT! crypto.com/nft/collection… via Crypto.com #NFTGiveaway #NFTCollection #NFT #NFTdrop #NFTshill #NFTs #BTC #art #nftart #NFTartist #ETH #CRO #NFTCommunity #NFTGiveaways #cryptocurrency

only at 👉 Crypto.com NFT the only official profile👉 crypto.com/nft/profile/sa… #NFT #NFTGiveaway #NFTs #NFTCollection #NFTcollectibles #nftart #NFTs #NFTartist #CRO #crofam #A01 by Saija at Crypto.com NFT! crypto.com/nft/collection… via Crypto.com


we are back 💛 only at 👉 Crypto.com NFT the only official profile👉 crypto.com/nft/profile/sa… #NFT #NFTGiveaway #NFTs #NFTCollection #NFTcollectibles #nftart #NFTs #NFTartist #CRO #crofam


only at 👉 Crypto.com NFT the only official profile👉 crypto.com/nft/profile/sa… #NFT #NFTGiveaway #NFTs #NFTCollection #NFTcollectibles #nftart #NFTs #NFTartist #CRO #crofam

only at 👉 Crypto.com NFT the only official profile👉 crypto.com/nft/profile/sa… #A03 by Saija at Crypto.com NFT! crypto.com/nft/collection… via Crypto.com #NFT #NFTGiveaway #NFTs #NFTCollection #NFTcollectibles #nftart #NFTs #NFTartist #CRO #crofam


only at 👉 Crypto.com NFT the only official profile👉 crypto.com/nft/profile/sa… #A04 by Saija at Crypto.com NFT! crypto.com/nft/collection… via Crypto.com #NFT #NFTGiveaway #NFTs #NFTCollection #NFTcollectibles #nftart #NFTs #NFTartist #CRO #crofam

only at 👉 Crypto.com NFT the only official profile👉 crypto.com/nft/profile/sa… #NFT #NFTGiveaway #NFTs #NFTCollection #NFTcollectibles #nftart #NFTs #NFTartist #CRO #crofam
